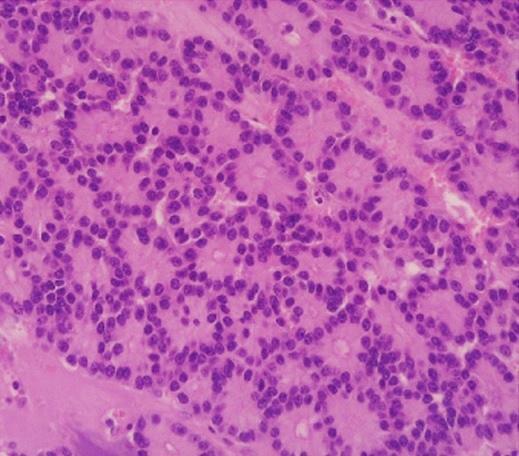
Pancreatic Carcinoma

Exocrine Pancreas
The exocrine pancreas is responsible for secretion of ions, water, and digestive enzymes into the duodenum of the gastrointestinal tract.
Endocrine Pancreas
The endocrine pancreas consists of groups of cells known as islets of Langerhans.
Each of the several cell types that make up an islet produces a different type of hormone.
Insulin is secreted by beta cells, which lie in the center of the islets.
In skeletal muscle and adipose tissue, where glucose absorption by GLUT4 lowers blood glucose, they are a key anabolic hormone that upregulates insulin-dependent glucose transporter protein (GLUT4).
Increased glucose uptake by tissues leads to increased glycogen synthesis, protein synthesis, and lipogenesis.
Alpha cells release glucagon, which competes with insulin to raise blood glucose levels in conditions like fasting by causing glycogenolysis and lipolysis.
Pathology of the pancreas includes:
- Annular pancreas
- Acute pancreatitis
- Chronic pancreatitis
- Pancreatic carcinoma
- Diabetes mellitus type 1
- Diabetes mellitus type 2
- Pancreatic endocrine neoplasms
Annular Pancreas
An annular pancreas is a developmental abnormality where the pancreas forms a ring around the duodenum.
A potential complication of an annular pancreas is duodenal obstruction.
Acute Pancreatitis
Acute pancreatitis occurs when the pancreatic parenchyma is auto digested by pancreatic enzymes, the result is acute inflammation and bleeding of the pancreas.
Trypsin that is activated too early causes other pancreatic enzymes to also become active.
Trypsin causes the peripancreatic fat to become necrotic, and the pancreas to experience liquefactive hemorrhagic necrosis.
The most important risk factors for acute pancreatitis are gall stones and alcohol consumption.
Risk factors for acute pancreatitis include:
- IGETSMASHED
- Idiopathic
- Gallstones
- Ethanol
- Trauma
- Steroids
- Mumps/malignancy
- Autoimmune
- Scorpion sting
- Hypercalcemia/hypertriglyceridemia
- Endoscopic retrograde cholangiopancreatography (ERCP)
- Drugs
Drugs that are known causes of acute pancreatitis include:
- Hydrochlorathiozide
- Azothiaprine
- Bactrim
- Pentamidine
- Didanosine
Clinical symptoms of acute pancreatitis include:
- Nausea
- Vomiting
- Periumbilical and flank hemorrhage
- Epigastric stomach pain that radiates to the back
Elevated serum lipase and amylase, where lipase is more specific for pancreatic injury, as well as the hypocalcemia that results when calcium is consumed during saponification in fat necrosis may occur.
Complications of acute pancreatitis include:
- Pancreatic pseudocyst
- Shock
- Disseminated intravascular coagulation (DIC)
- Acute respiratory distress syndrome (ARDS)
- Rupture
- Pancreatic abscess
E. coli usually causes pancreatic abscess, which manifests as stomach pain, a high temperature, and persistently increased amylase.
Chronic Pancreatitis
Chronic pancreatitis is the fibrosis of pancreatic parenchyma.
The most common cause of chronic pancreatitis is recurrent acute pancreatitis.
Clinical signs of chronic pancreatitis include:
- Back-radiating epigastric discomfort
- Pancreatic insufficiency
- Malabsorption
- Steatorrhea
- Deficits in fat-soluble vitamins
- Lipase and amylase are ineffective serologic indicators of chronic pancreatitis
Imaging of chronic pancreatitis typically shows:
- Dystrophic calcification of the pancreatic parenchyma
- Chain of lakes appearance brought on by pancreatic duct enlargement
Consequences of chronic pancreatitis include:
- Diabetes mellitus
- Pancreatic cancer
Pancreatic Carcinoma
Pancreatic carcinoma is classified as an adenocarcinoma that arises from the pancreatic ducts and is most frequently observed in older patients, who have an average age of 70.
Major risk factors for pancreatic carcinoma are:
- Smoking
- Chronic pancreatitis
Typically, clinical symptoms of pancreatic carcinoma show up later.
Symptoms of pancreatic carcinoma include:
- Epigastric pain
- Weight loss
- Obstructive jaundice
Clinical signs of pancreatic carcinoma also include pancreatitis and the so-called Trousseau sign, which is migratory thrombophlebitis.
In 10% of individuals, they show up as erythema, soreness, and edema in the extremities.
The serum tumor marker CA 19-9 is increased in pancreatic carcinoma.
Pancreatic carcinoma is treated by surgery, particularly the Whipple procedure.
Through the Whipple procedure surgery, the head and neck of the pancreas, the proximal duodenum, and the gallbladder are all removed together during this elaborate surgical resection.
Pancreatic carcinoma has a very poor prognosis, and the 1-year survival rate is less than 10%.
Diabetes Mellitus Type 1
Diabetes mellitus type 1 is due to an insulin deficit and the autoimmune destruction of beta cells by T lymphocytes.
Type 1 diabetes mellitus is a metabolic condition characterized by hyperglycemia.
Type 1 diabetes mellitus is characterized by inflammation of islets associated with HLA-DR3 and HLA-DR4.
Insulin autoantibodies are a common indicator of damage and may be present for years before a clinical condition manifests.
Clinical signs of insulin insufficiency show up in early manifestations of diabetes mellitus type 1.
When there is insufficient insulin, high serum glucose causes skeletal muscle and fat to absorb less glucose.
Unopposed glucagon causes gluconeogenesis, glycogenolysis, and lipolysis, which aggravates hyperglycemia further.
Symptoms of diabetes mellitus type 1 include:
- Polyurea
- Polyphagia
- Polydipsia
- Low muscle mass
- Weight loss
Hyperglycemia that is greater than the kidneys’ capacity to reabsorb glucose results in glycosuria.
Osmotic diuresis is caused by the extra filtered glucose.
Treatment of diabetes mellitus type 1 involves lifelong insulin use.
There is increased risk for diabetic ketoacidosis in diabetes mellitus type 1.
It is marked by high serum ketones, which frequently develops in response to stressors including infection and conditions where adrenaline promotes glucagon.
Increased lipolysis results in more free fatty acids (FFAs).
These free fatty acids (FFAs) are then transformed by the liver into the ketone molecules 3-hydroxybutyric acid and acetoacetic acid.
Diabetic ketoacidosis results in hyperglycemia > 300 mg/dL, anion gap metabolic acidosis, and hyperkalemia.
Diabetic ketoacidosis presents with:
- Kussmaul respirations
- Dehydration
- Nausea
- Vomiting
- Mental status changes
- Fruity smelling breath due to acetone
Fluids are administered to treat polyuria-induced dehydration, insulin is administered, and potassium-containing electrolytes are replaced.
Diabetes Mellitus Type 2
Diabetes mellitus type 2 is the end-organ insulin resistance leading to a metabolic disorder characterized by hyperglycemia.
With 90% of instances, diabetes mellitus type 2 is thought to impact 5–10% of the US population, and the incidence is still on the rise.
Diabetes mellitus type 2 is due to the reduced number of insulin receptors brought on by obesity.
Diabetes mellitus type 2 typically manifests in middle-aged obese individuals.
Early in the condition, insulin levels rise.
As beta cell exhaustion progresses, insulin insufficiency eventually appears.
Histology may show amyloid deposition in the islets.
Clinical symptoms of diabetes mellitus type 2 may include:
- Polyuria
- Polydipsia
- Hyperglycemia
Diagnosis of diabetes mellitus type 2 is made by measuring blood glucose levels.
The normal blood glucose value is 70 – 120 mg/dL.
Diabetes is diagnosed by of diabetes mellitus type 2:
- Fasting glucose is higher than 126 mg/dL
- Random glucose is higher than 200 mg/dL
- Glucose tolerance test shows a higher than 200 mg/dL serum glucose level two hours after glucose loading
- Hemoglobin A1c of 6.5% or greater
Treatment of diabetes mellitus type 2 involves:
- Weight loss
- Diet modification
- Exercise
- Metformin
- Sulfonylureas
- Exogenous insulin
Potential complications of diabetes mellitus type 2 include:
- Hyperosmolar nonketotic coma
Consequences of Diabetes
Consequences of diabetes include nonenzymatic glycosylation (NEG) of the vascular basement membrane.
Atherosclerosis and associated consequences are caused by a lack of large and medium-sized arteries.
Diabetic patients with peripheral vascular disease have the majority of non-traumatic amputations, while cardiovascular disease is the primary cause of death among diabetics.
Hyaline arteriolosclerosis, and renal arterioles that are involved cause glomerulosclerosis, which results in small, scarred kidneys with a granular surface.
The glomerular hyperfiltration damage caused by preferential efferent arteriole involvement proceeds to nephrotic syndrome and microalbuminuria as a result.
Histology of the kidney associated with diabetes shows Kimmelstiel-Wilson nodules in the glomeruli.
Schwann cells that myelinate peripheral nerves, the pericytes of retinal blood vessels, and the lens are open to glucose entry.
On the other hand, aldose reductase turns glucose into sorbitol, causing osmotic damage.
Excess glucose results in peripheral neuropathy, impotence, blindness, and cataracts.
In the developed world, diabetes is the main factor causing blindness.
Pancreatic Endocrine Neoplasms
Pancreatic endocrine neoplasms are tumors that originate from endocrine cells of the pancreas.
Less than 5% of pancreatic neoplasms are pancreatic endocrine neoplasms, which are islet cell tumors.
Along with pituitary adenomas and parathyroid hyperplasia, they are frequently a part of MEN I syndrome.
Insulinomas appear as sporadic hypoglycemia with altered mental status that is treated with glucose.
Blood glucose levels, which are usually less than 50 mg/dL, are used as diagnosis.
Gastrinomas manifest as Zollinger-Ellison syndrome, which are peptic ulcers that are resistant to treatment.
Multiple ulcers are likely, and they can spread into the jejunum.
Somatostatinomas present as achlorhydria due to inhibition of gastrin and cholelithiasis with steatorrhea due to inhibition of cholecystokinin.
Symptoms of somatostatinomas include:
- Watery diarrhea
- Hypokalemia
Achlorhydria are caused by VIPomas’ excessive vasoactive intestinal peptide secretion.